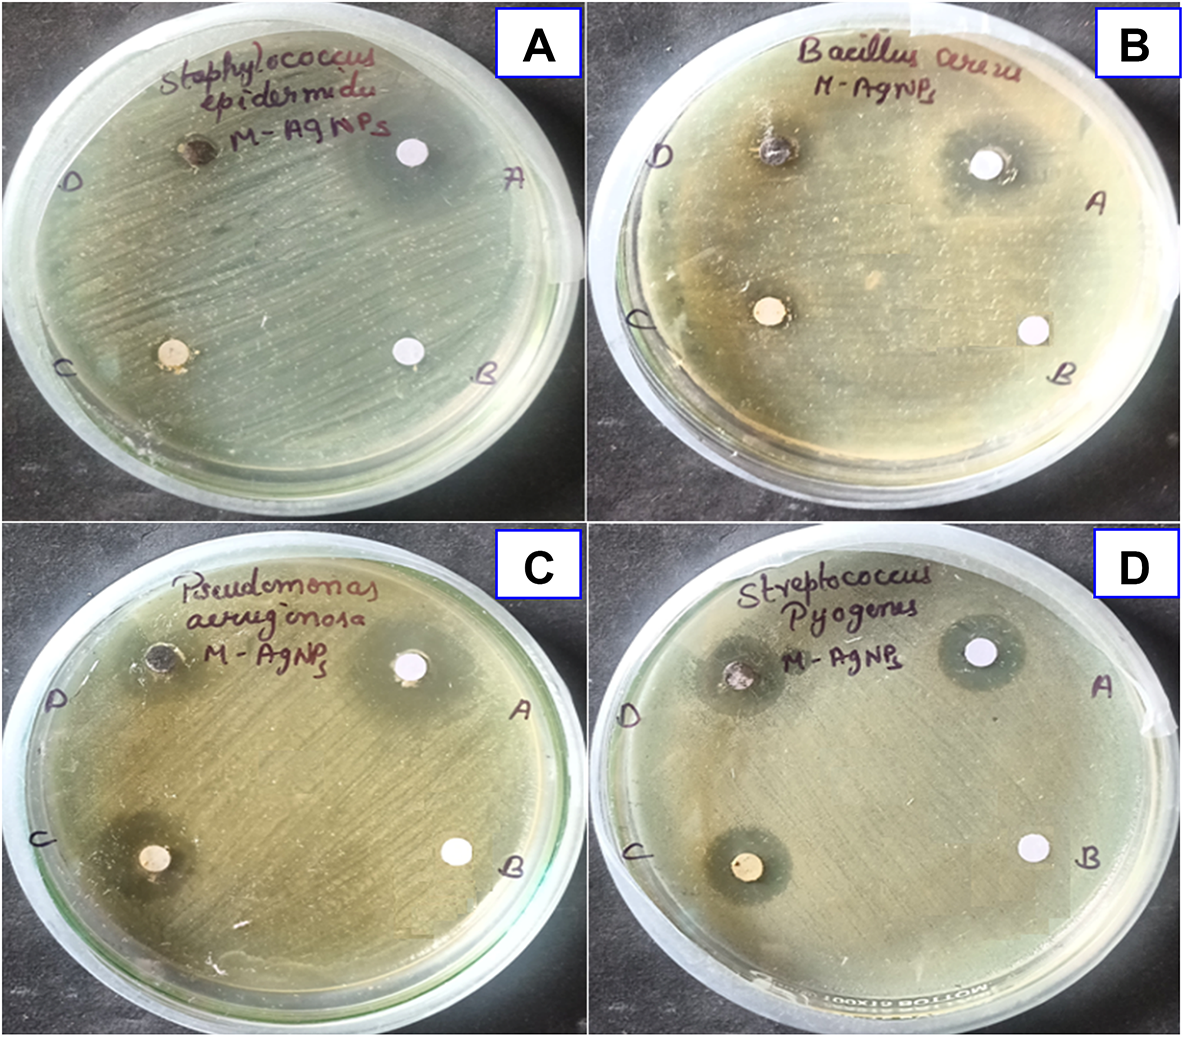
Fig. 6

Fig. 6

Antibacterial activity of the synthesized L-AgNPs, (A) Staphylococcus epidermis, (B) Bacillus cereus, (C) Pseudomonas aeruginosa, and (D) Streptococcus pyogenes.
Antibacterial activity of the synthesized L-AgNPs, (A) Staphylococcus epidermis, (B) Bacillus cereus, (C) Pseudomonas aeruginosa, and (D) Streptococcus pyogenes.